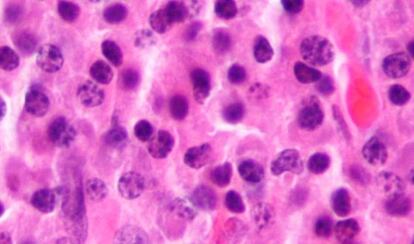

El sistema inmunitario se refuerza contra los cánceres de la sangre
"La inmunoterapia es una revolución que está evolucionando", afirma James Allison, uno de los pioneros de esta aproximación
La idea de combatir el cáncer con el propio sistema inmunitario del paciente "es vieja, de los años sesenta", afirma James Allison, reciente ganador del Premio Lasker (el Nobel americano) por su trabajo en la inmunoterapia. La idea es sencilla: conseguir que el mismo mecanismo que actúa contra virus, bacterias y hongos se deshaga de las células fuera de control que causan los tumores. Pero si el planteamiento es simple, llevarlo a la práctica ha sido muy complicado. Hasta 2010 no se obtuvieron los primeros resultados. "Una revolución", dice Allison, que en su presentación en sociedad fue revolucionario: el ipilimumab es capaz de multiplicar por más de cinco el tiempo de supervivencia del melanoma metastásico (de unos nueve meses a cinco años).
Curiosamente, son los tumores no sólidos, los que no se concentran en un órgano, los que están dando más alegrías en este abordaje. Un nuevo medicamento, el obinutuzumab, ha sido aprobado esta semana por el Ministerio de Sanidad español para tratar la leucemia linfática crónica (LLC), el más común de los tumores hematológicos, que afecta a 30 personas por cada millón de habitantes cada año. Actúa de dos maneras. Se trata de lo que se denomina un anticuerpo monoclonal. Esto quiere decir que está diseñado para unirse específicamente a las células tumorales, como hacen os anticuerpos que reconocen concretamente cada virus o bacteria que infecta un organismo. Una vez establecida la unión, actúa de dos maneras: señala la diana para el sistema inmunitario, y, también, él mismo tiene una cierta acción de destrucción de las células. El resultado es que la capacidad de "negativizar la enfermedad", de curarla, pasa del 3,3% con el tratamiento actual al 37,7%, dijo Francesc Bosch, el hospital Vall d'Hebron, al presentarlo. El riesgo de muerte se reduce un 61% frente a la medicación que se utiliza ahora.
Otro tratamiento que modula la respuesta inmune es el de la lenalidomida en pacientes con mieloma múltiple. Este medicamento es algo anterior, y ya se había probado en pacientes para los que había fracasado la terapia disponible. La lenalidomida, que es un regulador de la respuesta inmune, se administra combinada con dexametasona (una quimioterapia) y consigue, cuando se utiliza como primera opción, pasar del 13% de pacientes libres de progresión de la enfermedad a los cuatro años, a un 33%. Este uso se probó en España hace un mes.
Estos dos son los últimos ejemplos de una línea, la de estimular el sistema inmunitario, que solo acaba de empezar a dar resultados. Los últimos esfuerzos van más al fondo del proceso. "Las células cancerosas no solo se disfrazan para evitar la respuesta inmune. También envían señales para pararla", cuenta Allison que acaba de estar en un congreso de Oncología en la Clínica de la Universidad de Navarra. "Yo digo que le echa el freno". La idea del nuevo abordaje es evitar esa acción. "No se trata tanto de activar la respuesta, como de evitar que se pare", explica.
Ello es así porque los tratamientos dirigidos a las células tumorales antes o después se encuentran con un problema: que estas mutan y se hacen resistentes. Pero al actuar sobre sus señales este inconveniente se evita. "Para una terapia estándar, las mutaciones son malas; en este caso, son buenas", porque si la célula cambia deja de producir moléculas que frenen la respuesta inmune, o la modifica y entonces no tendrán ese efecto, añade Allison.
El especialista no ve un motivo para que estos abordajes hayan dado sus primeros resultados en cánceres de sangre. "También se están ensayando en los de pulmón y riñón. Está habiendo avances muy rápidos", dice.
El hecho de que se actúe sobre la inhibición del sistema inmune, que es un mecanismo general a muchos tumores, le lleva a aventurar otra cuestión: a diferencia de lo que sucede actualmente con los llamados tratamientos personalizados, "no habrá que desarrollar un tratamiento para cada tipo de cáncer. Probablemente con cuatro o cinco tengamos para muchas clases".
Esta última línea, la inmunoterapia propiamente dicha, aún tiene un amplio recorrido por delante: su combinación con las otras ya existentes, desde la cirugía, la quimioterapia y la radioterapia a los anticuerpos monoclonales o la medicina personalizada. "Esta conjunción es el futuro", dice Allison, y en "unos cinco años sabremos mejor su potencial real".
Solo hay una pega al optimismo de este abordaje. "Yo no veo que venga nada detrás que sea una nueva revolución", afirma Allison. Explotar lo que se tiene es, de momento, el mejor de los caminos.
Tu suscripción se está usando en otro dispositivo
¿Quieres añadir otro usuario a tu suscripción?
Si continúas leyendo en este dispositivo, no se podrá leer en el otro.
FlechaTu suscripción se está usando en otro dispositivo y solo puedes acceder a EL PAÍS desde un dispositivo a la vez.
Si quieres compartir tu cuenta, cambia tu suscripción a la modalidad Premium, así podrás añadir otro usuario. Cada uno accederá con su propia cuenta de email, lo que os permitirá personalizar vuestra experiencia en EL PAÍS.
¿Tienes una suscripción de empresa? Accede aquí para contratar más cuentas.
En el caso de no saber quién está usando tu cuenta, te recomendamos cambiar tu contraseña aquí.
Si decides continuar compartiendo tu cuenta, este mensaje se mostrará en tu dispositivo y en el de la otra persona que está usando tu cuenta de forma indefinida, afectando a tu experiencia de lectura. Puedes consultar aquí los términos y condiciones de la suscripción digital.





























































